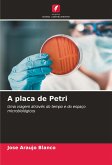
A placa de Petri A placa de Petri

As práticas para o laboratório de microbiologia ambiental permitirão aos utilizadores reconhecer e identificar a estrutura, metabolismo e classificação dos microrganismos de interesse ambiental, a fim de os introduzir na aplicação de técnicas de trabalho que se harmonizem com o ambiente e prepará-los para a investigação das interacções dinâmicas dos microrganismos. Inclui também um guia de análise microbiológica de alimentos com os requisitos para o processamento de matérias-primas, produto acabado e amostras de superfícies em contacto com os alimentos e o ambiente.
Bitte wählen Sie Ihr Anliegen aus.
Rechnungen
Retourenschein anfordern
Bestellstatus
Storno